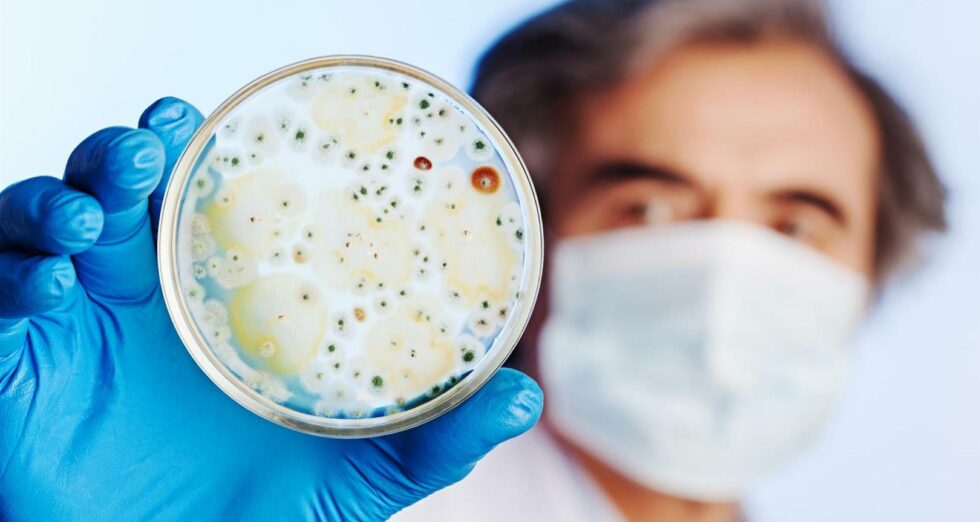
scientific-research-Large-1-980x522 scientific-research-Large-1-980x522

New Solutions
BIOMASTER™ AT 300
for water-based coatings
Biomaster™ AT 300
Biomaster™ AT 300 is an active odour control technology based on silver salt, a highly effective and naturally occurring anti-bacterial agent. It stops odour-causing bacteria from settling into any material. Without bacterial growth, there is no odour. Biomaster™ AT 300 is Oeko-tex® classes i-iv, EPA and bluesign® approved.
Physical Characteristics *
| Appearance | Off-white aqueous dispersion |
| pH | Approximately 7 |
| Dispersible | Preferably in warm water, with stiring |
* The values indicated in this publication describe typical properties and do not constitute specification limits.
Overview
Anti-bacterial agent
Silver salt
Stable in pH range 3-11
Evaluation of Biomaster™ 300 AT in water-based paint
Basic Properties

Results
To test the effectiveness Biomaster™ AT 300 in water-based coatings, our Regional Coatings Innovation Center conducted a side-by-side comparison with a white-based paint incorporating 0.5% Biomaster™ AT 300, and one batch of paint without the additive.
The results indicate that the paint containing 0.5% Biomaster™ AT 300 can destroy bacteria faster than without. We tested Biomaster™ AT 300’s efficiency for both E.coli and Staphylococcus aureus and the reduction of colony forming units (CFUs) was significantly increased with the addition of Biomaster.
Furthermore, the addition of Biomaster™ AT 300 in white-based paint does not affect basic paint properties, i.e. viscosity, pH, density, opacity, gloss.
The recommend dosage for Biomaster™ AT 300.
How Biomaster Works


Biomaster™
To reduce the spread of bacteria, surfaces need to be easy to clean and hygienic to minimize the risk of cross-contamination. If you can build in effective antimicrobial protection at the manufacturing point, this can be even easier and faster to integrate into a wide range of industries including healthcare, food and catering, public transport, packaging and more. Addmaster’s Biomaster™ does exactly this. By being added to any plastic, textile, paper, paint, or coatings at the point of manufacture, it provides durable product protection from bacterial growth.
Do you need help?
Our Regional Coating Innovation Center is the ideal place to get support. Our technical team can help you to test existing formulations and find new solutions. Send us a quick message and our experienced technicians will get directly in touch with you.
Related Articles & Trends
Olus & Jebsen & Jessen Strengthen Partnership for Next-Generation Feed Solutions in APAC
Netherlands-based feed additive manufacturer Olus is strengthening strategic partnership with leading distributor Jebsen & Jessen Ingredients across Asia-Pacific.
Jebsen & Jessen Ingredients at In-Cosmetics Asia 2025
This year, we’re bringing together cutting-edge ingredient science and deep formulation expertise. Visit us at Booth U11 to connect, explore, and co-create the next wave of beauty innovation.
From Skin to Smile: Enhancing Oral & Personal Care with Silica
On 2 October 2025, the Personal Care team at Jebsen & Jessen Vietnam successfully hosted a technical workshop at the company’s Ho Chi Minh City office, welcoming professionals from across the personal and oral care industry.